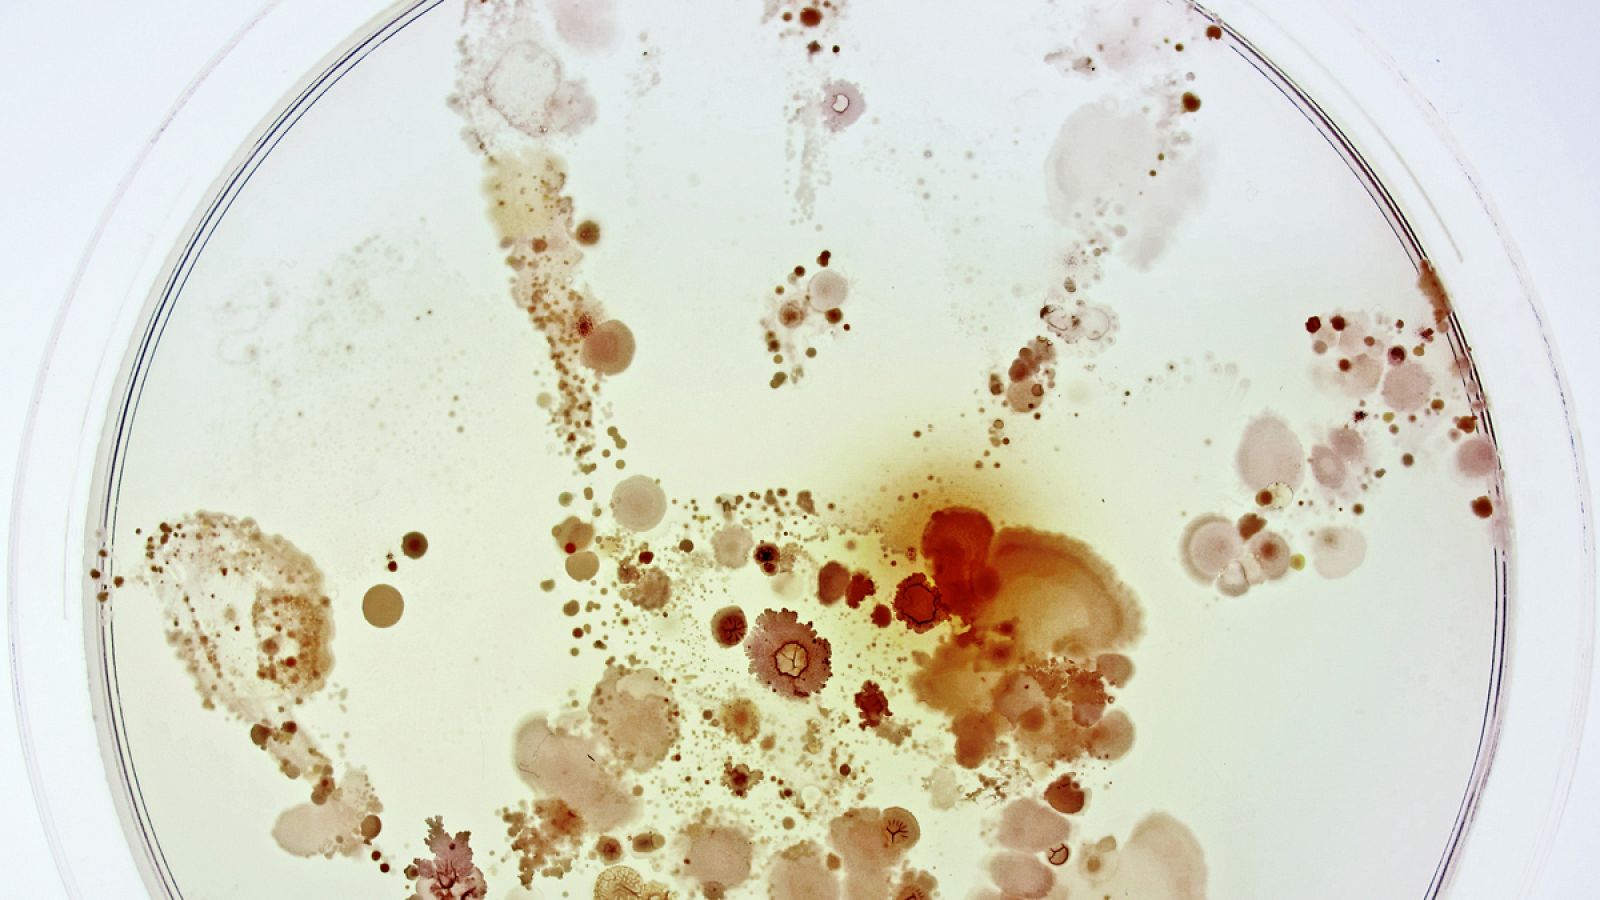
¿Qué esconde la mano de un niño?

Bacterias en la mano de una niña, la imagen ganadora de Fotciencia
- Un cristal de zeolita o una de la levadura de cerveza, otras fotografías premiadas
- Se trata de un certamen que pretende acercar la ciencia al público general
- Este año ha celebrado su 13ª edición

Una fotografía que refleja los microorganismos presentes en la mano de una niña, un cristal de zeolita utilizado para descontaminar agua o una de la levadura empleada en la elaboración de una cerveza artesana extremeña son algunas de las imágenes premiadas en el certamen Fotciencia.
El concurso está organizado por la Fundación Española para la Ciencia y la Tecnología (Fecyt) y el Consejo Superior de Investigaciones Científicas (CSIC), con la colaboración de la Fundación Jesús Serra, y este año se ha celebrado la 13ª edición. Este certamen pretende acercar la ciencia a la ciudadanía mediante una visión artística y estética, y se han presentado cerca de 700 imágenes.
La fotografía que ha recibido el primer premio en la categoría General lleva el título "¿Qué esconde la mano de un niño?" y en ella sus autores, Raúl Rivas y Lorena Celador, fotografiaron la huella de una niña de seis años que posó su mano sobre una placa de petri.
La imagen, tomada tras incubar la placa durante dos días, refleja colonias de levaduras y una gran diversidad de colonias de bacterias en distintas formas y tonalidades, ha informado la Fecyt en una nota. El objetivo, demostrar a alumnos de un colegio de Salamanca la importancia que tiene lavarse las manos y, al mismo tiempo, enseñarles que la presencia de microorganismos en la piel es algo habitual.
En la categoría Micro, la imagen ganadora ha sido "Mundo sostenible", de Ruth Sánchez y Antonio Tomás López. Ésta muestra un cristal de zeolita obtenido a partir de residuos que se utilizan para eliminar metales pesados en aguas contaminadas.
El accésit en la categoría General ha sido para "La primera sonrisa", de Víctor Rivera, una instantánea en la que se aprecia cómo embriones de rana adoptan diferentes posiciones dentro de cada uno de sus huevos.
El accésit en la categoría Micro ha recaído en "Vello", de María Carbajo: la imagen refleja la vellosidad que recubre a las larvas de un insecto conocido como 'escarabajo de las alfombras'.
El premio especial Instituto de Agricultura Sostenible ha sido para "Recolectoras de argán', de Eduardo Rivas, quien consiguió fotografiar a una cabra en un argán obteniendo sus frutos.
El premio especial Instituto de Agroquímica y Tecnología de Alimentos ha sido para "En la cerveza", de Pablo Muñoz y María Carbajo (premiada también en otra categoría). La fotografía corresponde a la levadura empleada en la elaboración de una cerveza artesana extremeña.
El premio La ciencia en el aula ha recaído en "La gota que colma la moneda", de Aránzazu Carnero Tallón y María de los Ángeles de Andrés Laguillo.





